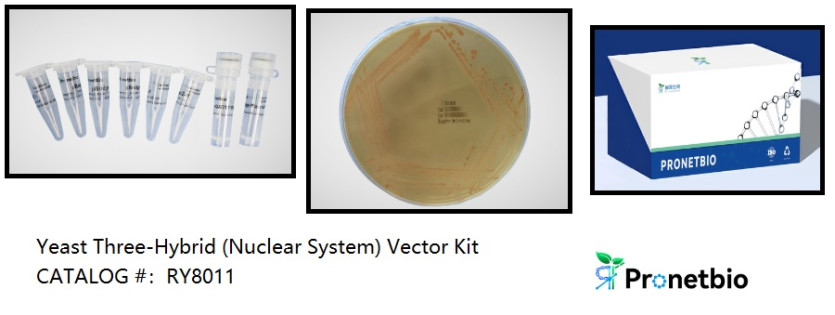

AI Bio 소식
[Pronet Biotech 공식 대리점]Yeast Three-Hybrid (Nuclear System) Vector Kit(RY8011)
- AI바이오허브 오래 전 2025.07.22 16:08 제품소개 인기
-
196
0
Yeast Three-Hybrid (Nuclear System) Vector Kit
CAT:RY8011
Product Overview
The Yeast Three-Hybrid (Nuclear System) Vector Kit (CAT: RY8011) is designed to facilitate protein-protein-small molecule and protein-DNA/RNA interaction studies with precision. Building on the Yeast Two-Hybrid (Y2H) system, this kit introduces the innovative pBridge plasmid, allowing simultaneous insertion and expression of two foreign proteins under methionine-deficient conditions.
Key features include:
Dual cloning sites (MCSI and MCSII) for inserting two proteins.
Precise gene regulation via the MET promoter, active only in methionine-deficient media.
Full compatibility with pGADT7 vectors for introducing additional genes of interest.
This kit is ideal for research applications such as transcription factor studies, nucleic acid-binding protein analysis, and drug discovery
Key Features
Advanced pBridge Plasmid Technology
Dual protein expression under methionine-deficient conditions.
Flexible cloning sites with optimized primer sets for amplification and sequencing.
Comprehensive Compatibility
Fully compatible with pGADT7 vectors and yeast strains like Y2HGold and Y187.
Robust Performance
Achieve reliable and reproducible results for complex interaction studies.
Detailed Protocols and Support
Includes experimental guidelines and troubleshooting tips to ensure success.
Applications
Protein-Protein-Small Molecule Interactions: Explore how small molecules modulate protein complexes.
Transcription Factor Studies: Investigate DNA-binding proteins and regulatory mechanisms.
RNA-Binding Protein Research: Uncover novel RNA-protein binding partners.
Drug Discovery: Screen for compounds targeting multi-protein complexes or regulatory pathways.
Experimental Guidelines
1. To ensure strain viability, streak the strain onto a YPDA agar plate before liquid culturing.
2. Store strains at -80°C with 50% glycerol to prevent repeated freeze-thaw cycles.
3. This product is for research use only and not for clinical, diagnostic, or therapeutic applications.
4. Maintain sterile conditions to avoid contamination.
Self-Prepared Materials
1. Sterile PCR tubes, tips, centrifuge tubes, shakers, incubators, and reagents like 50% PEG3350, 1M LiAc, X-α-Gal, and 3-AT.
2. (Optional from Pronetbio) Yeast media (YPDA, SD-Trp, SD-Trp/-Leu/-His), yeast plasmid extraction kits, and positive clone amplification kits.
FAQs of Y3H Kit
1. What is the difference between X-α-gal and X-gal?
X-gal is a substrate for β-galactosidase (LacZ), producing a blue product, while X-α-gal is specific for α-galactosidase (MEL1), used in yeast screening systems.
2. Why is 3-AT used in the screening process?
3-AT is a competitive inhibitor of histidine biosynthesis, suppressing HIS3 background expression and reducing false positives.
3. How do I preserve yeast strains after receipt?
Streak onto YPDA agar, isolate single colonies, and grow in liquid YPDA medium. Add sterile glycerol to 50% for long-term storage at -80°C.
견적 문의: aibiohub@aibiohub.co.kr 홈페이지: www.aibiohub.co.kr
견적 문의: https://aibiohub.co.kr/estimate/write
- 이전글[Quickzyme Bioscience 공식 대리점]Total collagen assay(QZBtotcol-1)2025.07.22
- 다음글[Progen Biotechnik 공식 대리점]AAV9 ELISA Control(PRAAV9-C)2025.07.22
댓글목록
등록된 댓글이 없습니다.